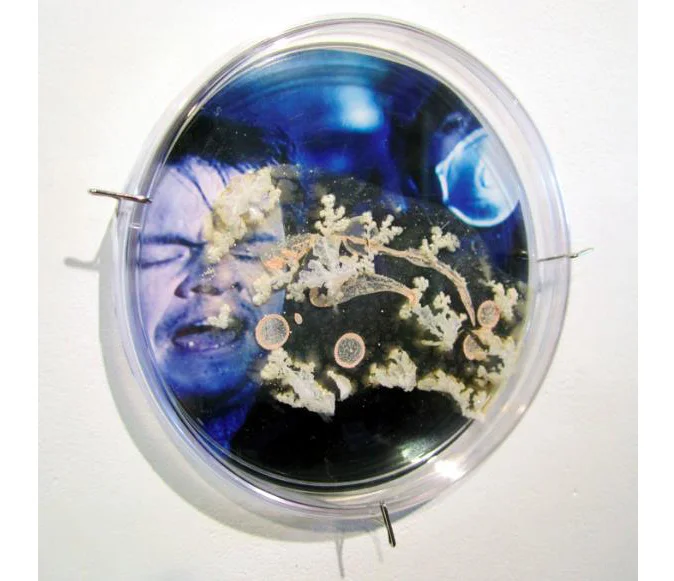

You're Custom Text Here
Inspired by an aesthetic of life in which art, science, medicine and ecology intersect, Elaine Whittaker’s transdisciplinary works consider biology as contemporary art practice. Her artworks explore the forces that make us human, from the foundational processes and materials needed to form an organism, to the microscopic world of cellular ecologies. Her practice is principally based in installation, and includes sculpture, painting, digital imagery and sound.
Recent works have centred on the aesthetics of disaster, the fear of pandemics, and on the body as a site of infection reflecting narratives and elements of anxiety that are found in popular culture, scientific research, and personal experience. Her art has been shown in solo and group exhibits, nationally and internationally, encompassing themes of water, blood, biotechnology, the genome, AIDS, cloning, climate change and infectious disease. These include, among others, Ontario Science Centre (Toronto, Canada), Science Gallery (Dublin, Ireland), ARC Gallery (Chicago, USA), Plug In Institute for Contemporary Art (Winnipeg, Canada), and the Contemporary Art Institute of Detroit (US).
Whittaker has been an invited participant in residencies, workshops and festivals on science, art and medicine, and a featured artist on websites such as Sciengage, MEDinART, and Photomediations Machine. Artworks have also appeared in literary, academic, and medical periodicals. She is a recipient of grants from the Canada Council for the Arts, the Ontario Arts Council, and the Toronto Arts Council, and holds a BFA (York University, Toronto), Art Diploma (Toronto School of Art), and BA (Carleton University, Ottawa).
In the fall of 2015 her work will be profiled in a new book by William Myers, entitled BioArt: Altered Realities, published by Thames & Hudson.
For the artist’s website and blogs, please visit:
www.etwhittaker.com
www.elainetw.blogspot.com
www.elainetwhittaker.tumblr.com
Inspired by an aesthetic of life in which art, science, medicine and ecology intersect, Elaine Whittaker’s transdisciplinary works consider biology as contemporary art practice. Her artworks explore the forces that make us human, from the foundational processes and materials needed to form an organism, to the microscopic world of cellular ecologies. Her practice is principally based in installation, and includes sculpture, painting, digital imagery and sound.
Recent works have centred on the aesthetics of disaster, the fear of pandemics, and on the body as a site of infection reflecting narratives and elements of anxiety that are found in popular culture, scientific research, and personal experience. Her art has been shown in solo and group exhibits, nationally and internationally, encompassing themes of water, blood, biotechnology, the genome, AIDS, cloning, climate change and infectious disease. These include, among others, Ontario Science Centre (Toronto, Canada), Science Gallery (Dublin, Ireland), ARC Gallery (Chicago, USA), Plug In Institute for Contemporary Art (Winnipeg, Canada), and the Contemporary Art Institute of Detroit (US).
Whittaker has been an invited participant in residencies, workshops and festivals on science, art and medicine, and a featured artist on websites such as Sciengage, MEDinART, and Photomediations Machine. Artworks have also appeared in literary, academic, and medical periodicals. She is a recipient of grants from the Canada Council for the Arts, the Ontario Arts Council, and the Toronto Arts Council, and holds a BFA (York University, Toronto), Art Diploma (Toronto School of Art), and BA (Carleton University, Ottawa).
In the fall of 2015 her work will be profiled in a new book by William Myers, entitled BioArt: Altered Realities, published by Thames & Hudson.
For the artist’s website and blogs, please visit:
www.etwhittaker.com
www.elainetw.blogspot.com
www.elainetwhittaker.tumblr.com
Contained (installation), 2018
Bed, bedside table, chair, crocheted shawl by Louise while in sanitorium, her books and music piano music sheets, personal items, table cloth, petri dishes with ink drawing and X-ray of lungs with TB
Fragile Forest, 2017
Grape stems, wax, partially decellularized maple leaves, pipette tips, cell culture plates
120”x 6”x 4”
Fragile Forest (detail), 2017
Grape stems, wax, partially decellularized maple leaves, pipette tips, cell culture plates
Fraught Air, 2018
Oxygen masks
150”x 96”x 3”
At Rest: Dwelling, 2018
Plastic tubing, sparrow feathers, test tubes, acrylic trays
6”x12”x3”
At Rest: Flight, 2018
Sparrow feathers, test tubes, Common Raven skull, acrylic trays
6”x12”x3”
Quiescent Growth, 2018
Partially decellularized maple keys, test tubes, cell culture plates, synthetic leaves
36”x22”x6”
Quiescent Growth (detail), 2018
Partially decellularized maple keys, test tubes, cell culture plates, synthetic leaves
Lungs of the Earth, 2018
Petri dishes, decellularized maple leaves with human lung epithelial cells
22”x 8”x 1”
Lungs of the Earth (detail), 2018
etri dishes, decellularized maple leaves with human lung epithelial cells
Airborne 1, 2017
Ink monotype on paper
12”x9”
Vestigial 2, 2017
Ink monotype on paper
11”x14”
Contained (detail), 2018
Petri dish, digital photo of X-ray of lungs with Tuberculosis, ink drawing
Tuberculosis, 2018
Slide with sample of human lung Mycobacterium Tuberculosis, digital image of slide on transparency film, acrylic trays
6”x12”x 3”
Shiverl, 2015
installation
Shiver, 2015
Installation
Shiver animation, 2015
Images: Elaine Whittaker
Editing & Music: Clive Whittaker
Photo by David Williams
Shiver, 2015
104" x 56" x 56"
2300 Petri dishes, grown salt crystals, wool, fishing wire, vinyl print, pipette tips, wire
Photo by David Williams
Shiver (detail 1), 2015
104" x 56" x 56"
Petri dishes, grown salt crystals, wool, fishing wire, vinyl print, pipette tips, wire
Photo by David Williams
Shiver (detail 2), 2015
104" x 56" x 56"
Petri dishes, grown salt crystals, wool, fishing wire, vinyl print, pipette tips, wire
Photo by David Williams
Shiver (detail 3), 2015
104" x 56" x 56"
Petri dishes, grown salt crystals, wool, fishing wire, vinyl print, pipette tips, wire
Photo by David Williams
Screened for Cholera, West Nile Virus, Plague, Tuberculosis, Malaria, SARS, Rotavirus, HIV/AIDS, Rabies, Influenza, 2015
16" x 16" (each print)
Screened for Rotavirus, 2015
Digital Print
16" x 16"
Screened for SARS, 2015
Digital Print
16" x 16"
Screened for Ebola, 2015
Variable dimensions, digital print, plaque halobacteria, petri dish
Photo by David Williams
Sierra Leone Ebola Graph (detail), 2015
Grown salt crystals, wool, wire, halobacteria, petri dish
20" x 20"
Photo by David Williams
I Caught it at The Movies, 2013
320" x 48" x 2"
Petri dishes, digital images, mylar, gouache, agar, Halobacterium sp. NRC-1
I Caught it at The Movies (detail, left side), 2013
320" x 48" x 2"
Petri dishes, digital images, mylar, gouache, agar, Halobacterium sp. NRC-1
I Caught it at The Movies (detail, centre), 2013
Petri dishes, digital images, mylar, gouache, agar, Halobacterium sp. NRC-1
320" x 48" x 2"
Andromeda Strain,, 2013
Petri dish, digital image, agar, Halobacterium, sp. NRC-1
6" x 6" x 2"
Contagion, 2013
Petri dish, digital image, agar, Halobacterium, sp. NRC-1
6" x 6" x 2"
Rabies, 2013
Petri dish, mylar, gouache, agar, Halobacterium sp. NRC-
6" x 6" x 2"
Ambient Plagues, 2013
Installation view
Microbes, Tools & Transmitters, 2013
Acrylic boxes with mixed media
31" x 7" x 6"
Other World 1-4 (series), 2013
Microscopy digital prints
Various sizes
Plague Doctor (series), 2013
Digital prints
Various sizes
Bacteria Grandeur, 2013
Wire and grown salt crystal
170" x 84" x 9"
Virus Colossus, 2013
Metal and vinyl tubing
75" x 75" x 3"
Become A Friend of the Gallery - Learn More